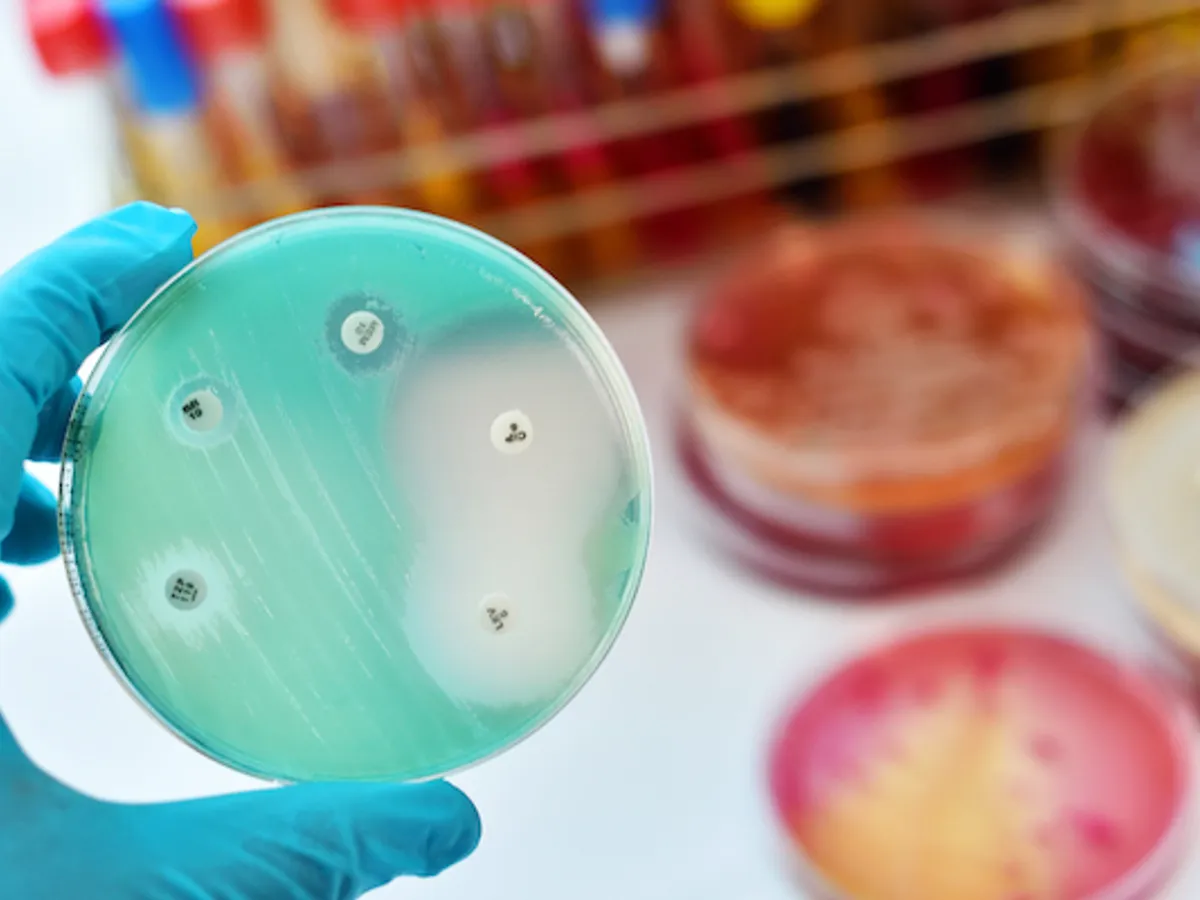

Românii iau antibioticele ca pe bomboane: 3% din populație consumă zilnic
Un document al ministerului Sănătății reconfirmă faptul că românii sunt printre cei mai mari consumatori de antibiotice din Uniunea Europeană. Ministerul asociază această situație cu infecțiile nosocomiale.
„Situația din România este ingrijoratoare; avem o cunoaștere limitată a dimensiunilor sale în țara noastră, datele disponibile indica un nivel crescut al acestei rezistente și au fost parcurși prea puțini pași (inclusiv în comparație cu celelalte state europene) către controlul rezistenței microbiene.
Citește și: Britanicii, după retragerea SUA: „Suntem gata să lansăm atacuri împotriva ISIS-K”
Perioada actuală poate fi caracterizată prin:
- Nivel ridicat al consumului de AB (între primele cinci state din Europa, cu 70% peste media europeană; ceva mai mult de 3% din populația României folosește antibiotice în fiecare zi)
- Utilizarea frecventa nejustificata de antibiotice cu risc sporit de selectare a rezistenței și de producere a dismicrobismelor; sunt utilizate în exces antibiotice de rezerva – cu spectru ultralarg; sunt utilizate mai puțin antibiotice care stimulează mai puțin rezistența microbiană și apariția de dismicrobisme.
- Rezistența bacteriană: cunoaștere lacunară, dar nivel mare pe datele existente (primele locuri în Europa la germeni importanți în infecții nosocomiale și comunitare: MRSA, Pseudomonas aeruginosa, Acinetobacter, Klebsiella pneumoniae, Escherichia coli)
- Infecții nosocomiale (cele apărute la pacienți care sunt/au fost recent internați) reprezintă o categorie importantă prin faptul că sunt produse mult mai frecvent de germeni multirezistenți și de aceea uneori necesită tratamente antibiotice de rezerva; problemele majore existente sunt: subraportarea majoră, măsuri insuficiente de control al acestor infecții (afirmație care poate fi susținută prin evoluția emergentă și endemicizarea infecțiilor cu Clostridium difficile în spitalele din România)”, se arată într-o notă de fundamentare la un proiect de hotărâre de guvern prin care se propune înființarea unui consiliu care să monitorizeze situația infecțiilor nosocomiale.
Ministerul Sănătății arată că în perioada ianuarie-martie 2021 au fost înregistrate 7974 cazuri noi de infecţii interioare, din care: 429 cazuri determinate de septicemie, 3435 cazuri determinate de infecții respiratorii, 2361 de cazuri determinate de infecții digestive, 769 cazuri determinate de infecții urinare, 347 cazuri determinate de plaga chirurgicală, etc.
Potrivit datelor furnizate de Institutul Național de Sănătate Publică, în anul 2020 au fost raportate 4814 infecții asociate asistenței medicale, semnificativ mai puține decât în anul 2019.
Potrivit Insitutul Național de Sănătate Publică, în anul 2017, în România au fost raportate, în total, 19.607 infecții spitalicești, cele mai multe fiind în București - 5.246, pe locul al doilea este județul Iași, cu 2.469 de infecții spitalicești raportate, pe locul al treilea este Clujul, cu 1.720 de infecții raportate în anul 2017. Următoarele locuri în topul județelor care raportează cele mai multe infecții sunt: Timiș (1.525), Sibiu (655), Galați (547), Dâmbovița (439), Suceava (429), Brașov (406) și Mureș (401). De cealaltă parte, topul 10 județelor care au raportat cele mai puține infecții: Covasna (40), Ialomița (41), Giurgiu (55), Gorj (58), Tulcea (62), Vâlcea (68), Teleorman (81), Mehedinți (100), Ilfov (121) și Călărași (124).
Citește și: Interlopul Mircea Nebunu către Bebino: 50 de ani să-ți dea ăștia, sclavule. Tu i-ai legat pe toți
În ceea ce privește primul semestru al anului 2018, numărul total al infecțiilor raportate a fost de 9.805.Cele mai multe au fost raportate în București (2.412), capitala fiind urmată de Iași (1.289), Timiș (805), Cluj (711), Sibiu (311), Satu Mare (231), Galați (229), Prahova (220), Brașov (212), Mureș și Arad (câte 211). Cele mai puține infecții au fost raportate în prima jumătate a anului 2018 în spitalele din județele Ilfov (14), Ialomița (28), Gorj (33), Călărași (34), Covasna (36), Giurgiu (39), Botoșani (50), Tulcea (53), Sălaj (61) și Vâlcea (64).